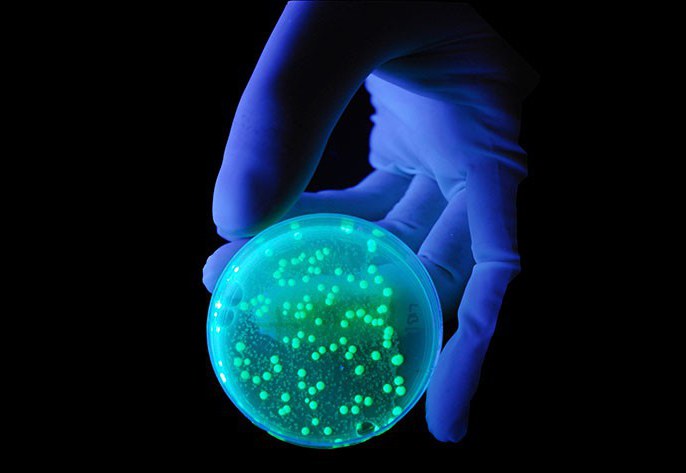

به گزارش نیواطلس، باکتریهای مقاوم به آنتیبیوتیک، در دهههای آینده به یک تهدید بزرگ برای سلامتی تبدیل میشوند اما اکنون مشخص شده که ممکن است آنتیبیوتیکهای جدیدی در بدن ما وجود داشته باشند. پژوهشگران "دانشگاه پنسیلوانیا" (UPenn)، از یک الگوریتم جستجو برای یافتن دهها پپتید ضد میکروبی استفاده کردهاند که به صورت بالقوه در بدن انسان وجود دارند.
همان گونه که باکتریهای در حال تکامل نسبت به داروهای ما مقاومت میکنند، عفونتهایی که پیشتر قابل درمان بودهاند، دوباره خطرناک میشوند. پیشبینی میشود که این ابرمیکروبها تا سال ۲۰۵۰ ، سالانه مرگ ۱۰ میلیون نفر را به همراه داشته باشند. دانشمندان با توجه به نزدیک شدن آخرین خط دفاعی ما به شکست خوردن، در موارد گوناگونی از جمله چای سبز، گلهای تنباکو، شیر مادر، زهر مار زنگی، پوست قورباغه، قارچها و حتی شیر یک پستاندار موسوم به "نوکاردکی" یا پلاتیپوس" (Platypus) به دنبال داروهای جدید هستند.
پژوهشگران در این پروژه، به دنبال پپتیدهای ضد میکروبی جدیدی در بدن انسان بودند. آنها از یک الگوریتم برای یافتن پپتیدهایی با خواص ضد میکروبی در "پروتئوم" (Proteome) انسانی استفاده کردند. پروتئوم، به کل پروتئینهایی گفته میشود که طی زمان مشخصی در یک سلول بیان میشوند.
این گروه پژوهشی، کار خود را با بررسی پروتئوم آغاز کردند تا پپتیدهایی را پیدا کنند که ویژگیهایی مشابه همه پپتیدهای ضد میکروبی دارند؛ یعنی طول آنها بین هشت تا ۵۰ آمینواسید است، بار مثبت دارند و حاوی قطعات آبگریز و آبدوست هستند. پپتیدهایی که پژوهشگران پیدا کردند، هیچ ارتباطی با سیستم ایمنی نداشتند و همین باعث شد که پژوهشگران آنها را با عنوان "پپتیدهای رمزگذاری شده" معرفی کنند.
سپس پژوهشگران، ۵۵ مورد از پپتیدها را انتخاب کردند و به بررسی تاثیر آنها در برابر هشت باکتری بیماریزا از جمله "اشریشیا کلی" (E. coli)، "کلبسیلا پنومونیه" (Klebsiella pneumoniae)، "سودوموناس آئروژینوزا" (Pseudomonas aeruginosa) و "استافیلوکوکوس اورئوس" (Staphylococcus aureus) پرداختند. عفونت ناشی از این باکتریها، اغلب به بستری شدن در بیمارستان میانجامد و درمان آن دشوار است.
"سزار د لا فوئنته" (César de la Fuente)، پژوهشگر ارشد این پروژه گفت: ما دریافتیم که ۶۳.۶ درصد از این ۵۵ پپتید رمزگذاری شده، فعالیت ضد میکروبی نشان میدهند. جالب اینجاست که این پپتیدها نه تنها با عفونت برخی از مضرترین باکتریهای جهان مبارزه کردند، بلکه ارگانیسمهای همسو را در روده و پوست هدف قرار دادند که برای ما سودمند هستند. ما حدس میزنیم که این میتواند نشاندهنده نقش تعدیلکننده یک میکروبیوتا باشد که در این پپتیدها وجود دارد.
زمانی که پپتیدهای ضد میکروبی با سایر پپتیدهای همان ناحیه از بدن در یک گروه قرار گرفتند، بهتر عمل کردند و قدرت ضد میکروبی آنها تا ۱۰۰ برابر افزایش یافت. پژوهشگران در آزمایشهایی که روی موشها انجام شد، متوجه شدند که پپتیدهای ضد میکروبی جدید، به خوبی آنتیبیوتیکهای موجود عمل میکنند؛ بدون اینکه هیچ نشانهای از سمی بودن را پدید آورند.
مجموعه بعدی آزمایشها بررسی کردند که آیا این پپتیدهای رمزگذاری شده، روی باکتریها تأثیر میگذارند تا مقاومت بیشتری را ایجاد کنند یا خیر. نتایج این آزمایشها نیز امیدوارکننده به نظر میرسد.
فوئنته ادامه داد: ما دریافتیم که این مولکولهای رمزگذاری شده، با نفوذ به غشای بیرونی باکتریها که یک اندامک جداییناپذیر برای بقا است، به آنها حمله میکنند. باکتریها برای مقاومت در برابر این نفوذ مخربتر به غشای بیرونی، به انرژی زیاد و چندین نسل جهش نیاز دارند. این موضوع نشان میدهد که این پپتیدهای تازه کشف شده، گزینه خوبی برای تبدیل شدن به آنتیبیوتیکهای پایدار هستند.
به گفته پژوهشگران، این پروژه نه تنها میتواند به تولید آنتیبیوتیک های طبیعی جدیدی برای مقابله با تهدید فزاینده ابرمیکروبها کمک کند، بلکه روش مورد استفاده برای یافتن آنها نیز میتواند به کشف مولکول های پنهان برای درمان سایر بیماریها بیانجامد.
این پژوهش، در "Nature Biomedical Engineering" به چاپ رسید.
منبع:ایسنا